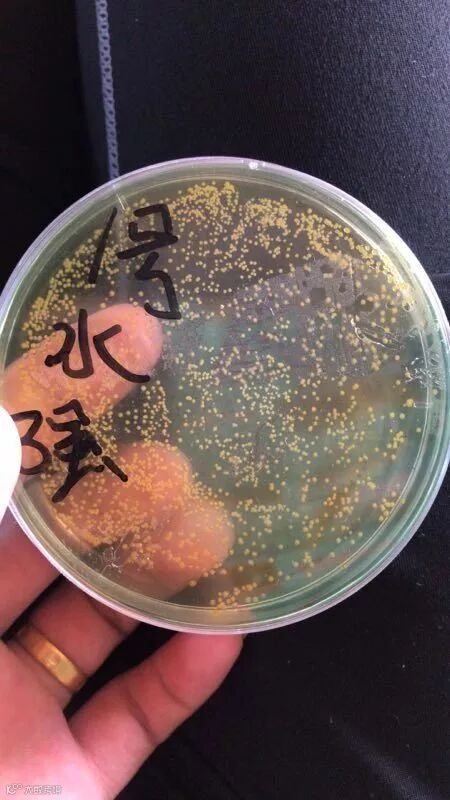
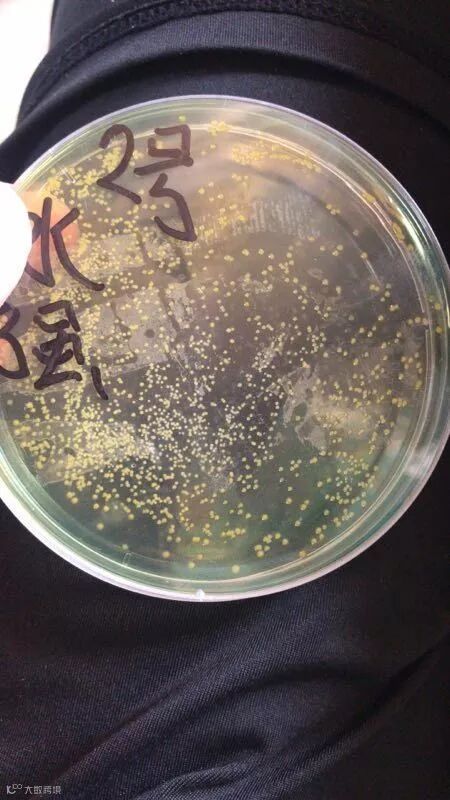

案例信息
养殖地点:霞浦江沙
面积:4.5亩(4口池)水位1.5米
水质情况:暗、寡、泡沫拖尾长、悬浮物多
7月29日,水色暗,寡,泡沫拖尾长,悬浮物多,对虾断须,红须,白便,慢料,肝微萎缩,检测黄菌严重超标。
7月30日上午底毒消250克+护底宝300克,后,弧光7克/亩米。
8月3日抗应激vc250克+离子钙100克;抗炎精华膏350克+碘中碘170克(一天一次连用两天);内服乳酸菌5%+裂菌5%+生命元2.5%(一日一餐连用3天);7日检测黄菌基本清除。白便消失。




 正洋生物
正洋生物案例信息
养殖地点:霞浦江沙
面积:4.5亩(4口池)水位1.5米
水质情况:暗、寡、泡沫拖尾长、悬浮物多
7月29日,水色暗,寡,泡沫拖尾长,悬浮物多,对虾断须,红须,白便,慢料,肝微萎缩,检测黄菌严重超标。
7月30日上午底毒消250克+护底宝300克,后,弧光7克/亩米。
8月3日抗应激vc250克+离子钙100克;抗炎精华膏350克+碘中碘170克(一天一次连用两天);内服乳酸菌5%+裂菌5%+生命元2.5%(一日一餐连用3天);7日检测黄菌基本清除。白便消失。